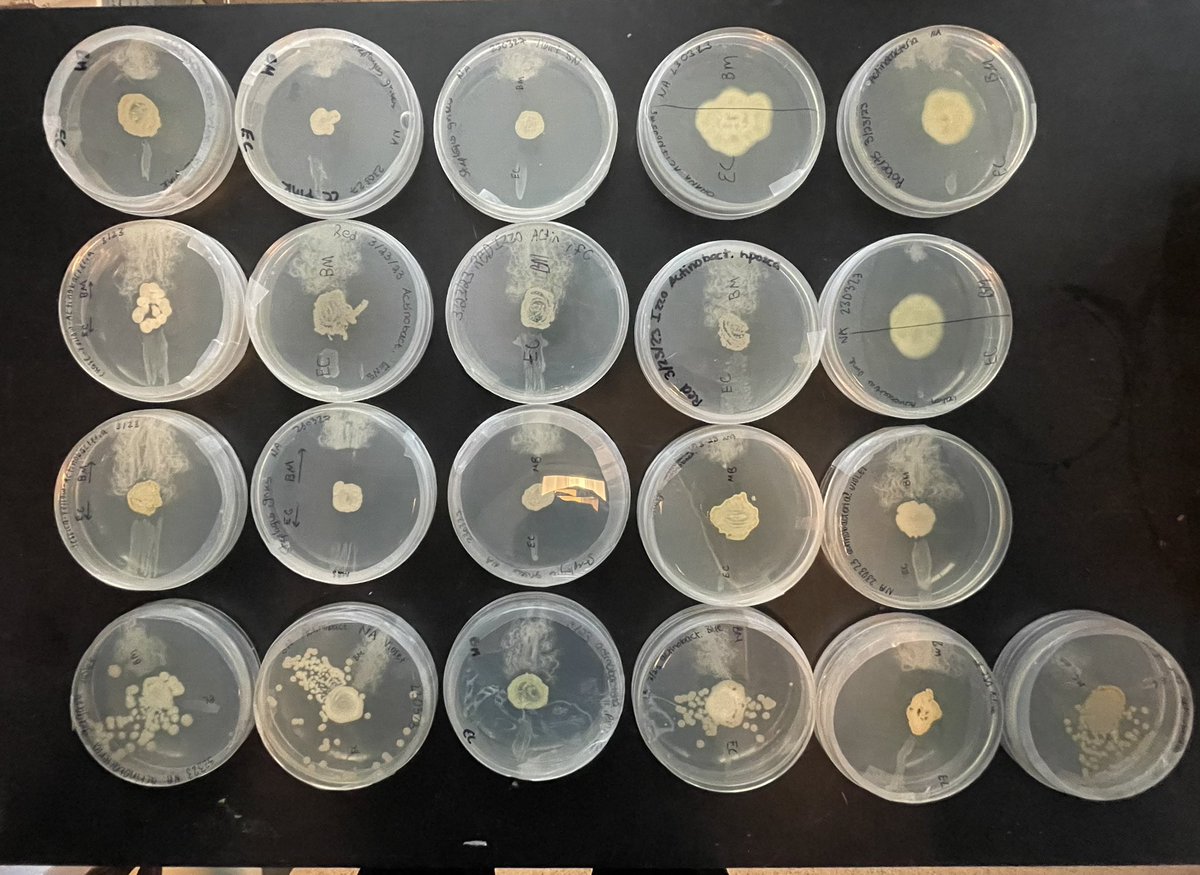
Actinobacteria isolated from Elon campus soils (center of plate) by Micro class showing range of antibiotic production  vs G+ (top) and G- (bot) <a href="/ElonBiology/">Elon Biology</a>

Antonio Izzo
@antonioizzo2
Associate Professor of Biology, Molecular Microbial Ecologist, sports and tech enthusiast. adizzolab.wordpress.com
ID: 326295603
29-06-2011 17:53:34
3,3K Tweet
471 Followers
828 Following






Antonio Izzo Thanks for your gift to the Department of Biology in honor of #ElonDay!

Actinobacteria isolated from Elon campus soils (center of plate) by Micro class showing range of antibiotic production vs G+ (top) and G- (bot) Elon Biology

2023 USA Ultimate D-I College Championships: Streaming Schedule, How to Watch -> ultiworld.com/2023/05/24/202…
















